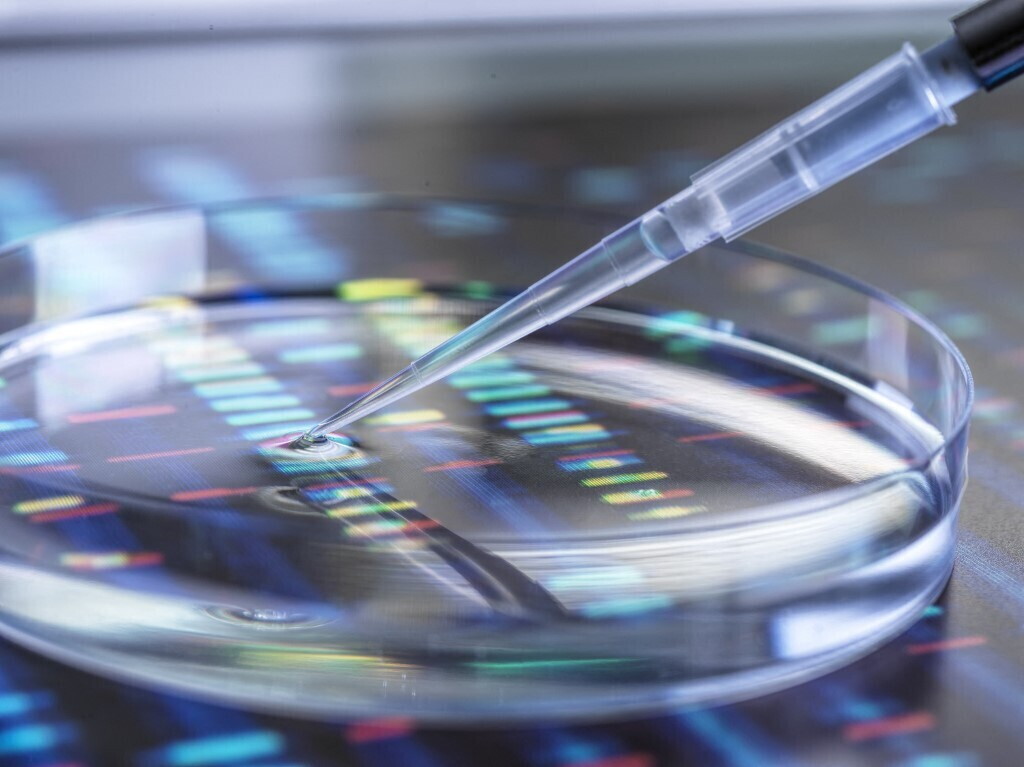

AGI – Se fino a pochi anni fa la “dieta del momento” prometteva miracoli a chiunque la seguisse, oggi la scienza ci dice il contrario. La biologia non è democratica: ciò che per me è un “superfood“, per il tuo metabolismo potrebbe essere un rallentatore infiammatorio. Benvenuti nell’era della “nutrizione di precisione”.
La nutrigenomica non è una semplice dieta, ma lo studio di come il cibo interagisce con i nostri geni. Non parliamo di fantascienza, ma di test ormai accessibili che analizzano piccoli frammenti del nostro DNA (i polimorfismi) per capire come processiamo i nutrienti.
I pilastri della dieta su misura
Tre sono i pilastri della dieta su misura. Metabolismo dei macronutrienti: c’è chi brucia i grassi con efficienza ma fatica con i carboidrati complessi, e viceversa. Infiammazione e Detox: la capacità del fegato di eliminare le tossine o la predisposizione a stati infiammatori cronici legati a certi alimenti. Sensibilità “nascoste”: non solo celiachia, ma lievi intolleranze genetiche al lattosio, alla caffeina o al sodio che influenzano ritenzione idrica e pressione arteriosa.
Tecnologia e nutrigenomica
Rispetto ai primi test rudimentali di qualche anno fa, oggi il processo è diventato fluido e integrato con la tecnologia indossabile (smartwatch e anelli smart). Poi ci sono il prelievo, un semplice tampone salivare inviato per posta. E l’analisi dove il laboratorio sequenzia le varianti genetiche legate alla nutrizione. Nelle App dedicate, i risultati non sono più un PDF illeggibile, ma un’interfaccia dinamica che si aggiorna. Se il test dice che sintetizzi male la Vitamina D, l’app ti suggerirà ricette specifiche e monitorerà (tramite i sensori dello smartwatch) la tua esposizione solare.
I benefici della dieta personalizzata
Studi recenti confermano che chi segue una dieta basata sul proprio profilo genetico ha una probabilità del 33% superiore di mantenere il peso forma a lungo termine rispetto a chi segue una dieta ipocalorica standard. Perché milioni di persone stanno investendo in questo approccio? La risposta non è solo la prova costume. Si evitano, infatti, i picchi glicemici personalizzando l’assunzione di zuccheri ed elimina i colpi di sonno post-pranzo. Scegliere gli antiossidanti giusti per il proprio profilo genetico aiuta a contrastare i radicali liberi in modo mirato. Esiste poi una correlazione diretta tra salute intestinale (microbioma) e lucidità cognitiva. La dieta su misura ottimizza questo asse.
Oltre il DNA: stile di vita e supporto esperto
Nonostante l’entusiasmo, gli esperti avvertono: il DNA non è il destino. I geni caricano la pistola, ma è lo stile di vita a premere il grilletto. Affidarsi esclusivamente a un test online senza il supporto di un nutrizionista o di un medico esperto può essere fuorviante. La genetica ci dà la “mappa”, ma la strada la percorriamo con le nostre abitudini quotidiane, lo sport e la gestione dello stress. La dieta su misura rappresenta il definitivo superamento del concetto di “privazione”. Non si tratta più di mangiare meno, ma di mangiare meglio per sé. In un mondo saturato da cibi ultra-processati, tornare all’ascolto del proprio corpo, supportati dalla tecnologia, è forse l’atto più rivoluzionario che possiamo compiere per la nostra salute.